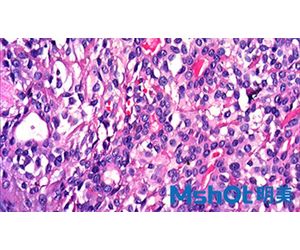

Guangzhou Micro-Shot Technology Co., Ltd
- Home
- Companies
- Guangzhou Micro-Shot Technology Co., ...
- Products
- MSHOT - Model ML10 - Entry-level ...
MSHOT - Model ML10 -Entry-level biological microscope ML10
Biological microscope ML10 is a basic optical biological microscope with LED transmitted illumination. It is equipment with trinocular head supports microscope camera. The biological microscope is easy to operate. It's an ideal laboratory microscope for education and widely used in the field of agriculture.Most popular related searches
biological microscope
microscopy
microscopy camera
laboratory microscope
camera microscope
optical microscopy
trinocular microscope
microscopy laboratory
microscope illuminator
microscope illumination
- Trinocular tube 50%:50% light division, can see image in eyepiece and PC at the same time.
- Articulated head, anti-fungus, 360°rotatable.
- 160mm tube length.
- LED light source with 20,000 hours working life.
- Bottom stage width 170mm, length 22mm, save store space.
